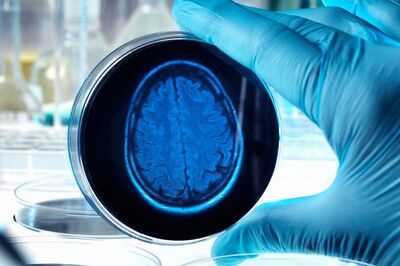

The NHS is "simply not ready" for a new class of drugs able to revolutionise treatment of Alzheimer’s disease, experts have warned.
It comes as a group of 40 researchers said the Alzheimer's landscape is set to transform in the coming years thanks to new drugs and blood tests. Writing in a series of papers published in the Lancet, they warn that without better early diagnosis these "major innovations" will not be realised.
It comes after two new drugs have emerged as the first shown to tackle Alzheimer’s but only if administered at the earliest stages of the disease, before irreversible brain deterioration.
READ MORE: Dementia expert describes 'red flag' memory problems you should really worry about
READ MORE: Over 100 new dementia drugs could be 'start of cure' as experts hail breakthrough
Dr Richard Oakley, associate director of Research and Innovation at Alzheimer's Society, said the series of papers "mark the beginning of a new era in Alzheimer's disease diagnosis and treatment". He said: "The painful truth is that the NHS is simply not ready and isn't keeping pace with the science. We now run the very real risk that people living with dementia will miss out on the opportunity to benefit from these big breakthroughs.
"It's vital that the UK government keeps its eye on the ball so people with dementia aren't left behind. We want to see better access to early diagnosis so people don't miss out on the narrow window of eligibility to benefit from treatments which can slow Alzheimer's disease. Preparing for future treatments will take a society of researchers, clinicians and decision-makers."
Alzheimer's disease is the most common form of dementia. One in three people born in the UK today will develop dementia in their lifetime. By 2040 around 1.4 million people in the UK could be living with the condition.

NHS patients are currently trialling a new blood test for Alzheimer's, with results expected within three years. There are fears the NHS does not have the capacity and expertise to roll out any successful blood test at scale.
Lead author Professor Giovanni Frisoni, of the University of Geneva in Switzerland, said: "As it happens in all medical revolutions, it's not something that takes place overnight, it will take place over years, but the path has clearly been taken, and there's no way back.
"Blood tests, biological drugs for Alzheimer's disease, and prevention interventions are propelling care into entirely new and exciting territory.”
David Thomas, head of policy at Alzheimer's Research UK, said: "In under a decade, the number of experimental treatments for Alzheimer's, the leading cause of dementia, has doubled, and our understanding of the disease has advanced faster than ever before.
"Yet as these papers highlight, scientific momentum alone is not enough. It demonstrates the major implications for how our health services are organised. Turning research breakthroughs into change for people affected by dementia is a challenge that governments and health service leaders must address."
New Alzheimer's drugs donanemab and lecanemab have been licensed for use in the UK, but will not be made available on the NHS after spending watchdog the National Institute for Health and Care Excellence (Nice) deemed their benefits "too small" to justify their cost. However more effective versions of the drugs are expected to follow.

They have both come with a known side effect of brain swelling or bleeding. Lecanemab could reportedly cost around £21,000 per person each year through private clinics in the UK if it is licensed.
The experts writing in the Lancet say the medications slow the progression of Alzheimer's as effectively as treatments for other conditions such as cancer, rheumatoid arthritis and multiple sclerosis.
An NHS spokesperson said: "The NHS is currently giving patients access to every approved, evidence-based and cost-effective approach for dementia diagnosis and treatment, and we have been working to ensure local services are ready to roll out any new treatments for early-stage Alzheimer's which are approved by Nice in the future."
You may also like
Commerce Minister Goyal meets US Trade Representative Greer in New York
Not getting GST cut benefits? Call helpline
H-1B visa move to impact India-US trade talks, says former senior Commerce Dept official (IANS Exclusive)
Bhopal collector issues safety directives for Garba and Dandiya events
Cobbled town with two very famous residents has 'best spot in the world for autumn'